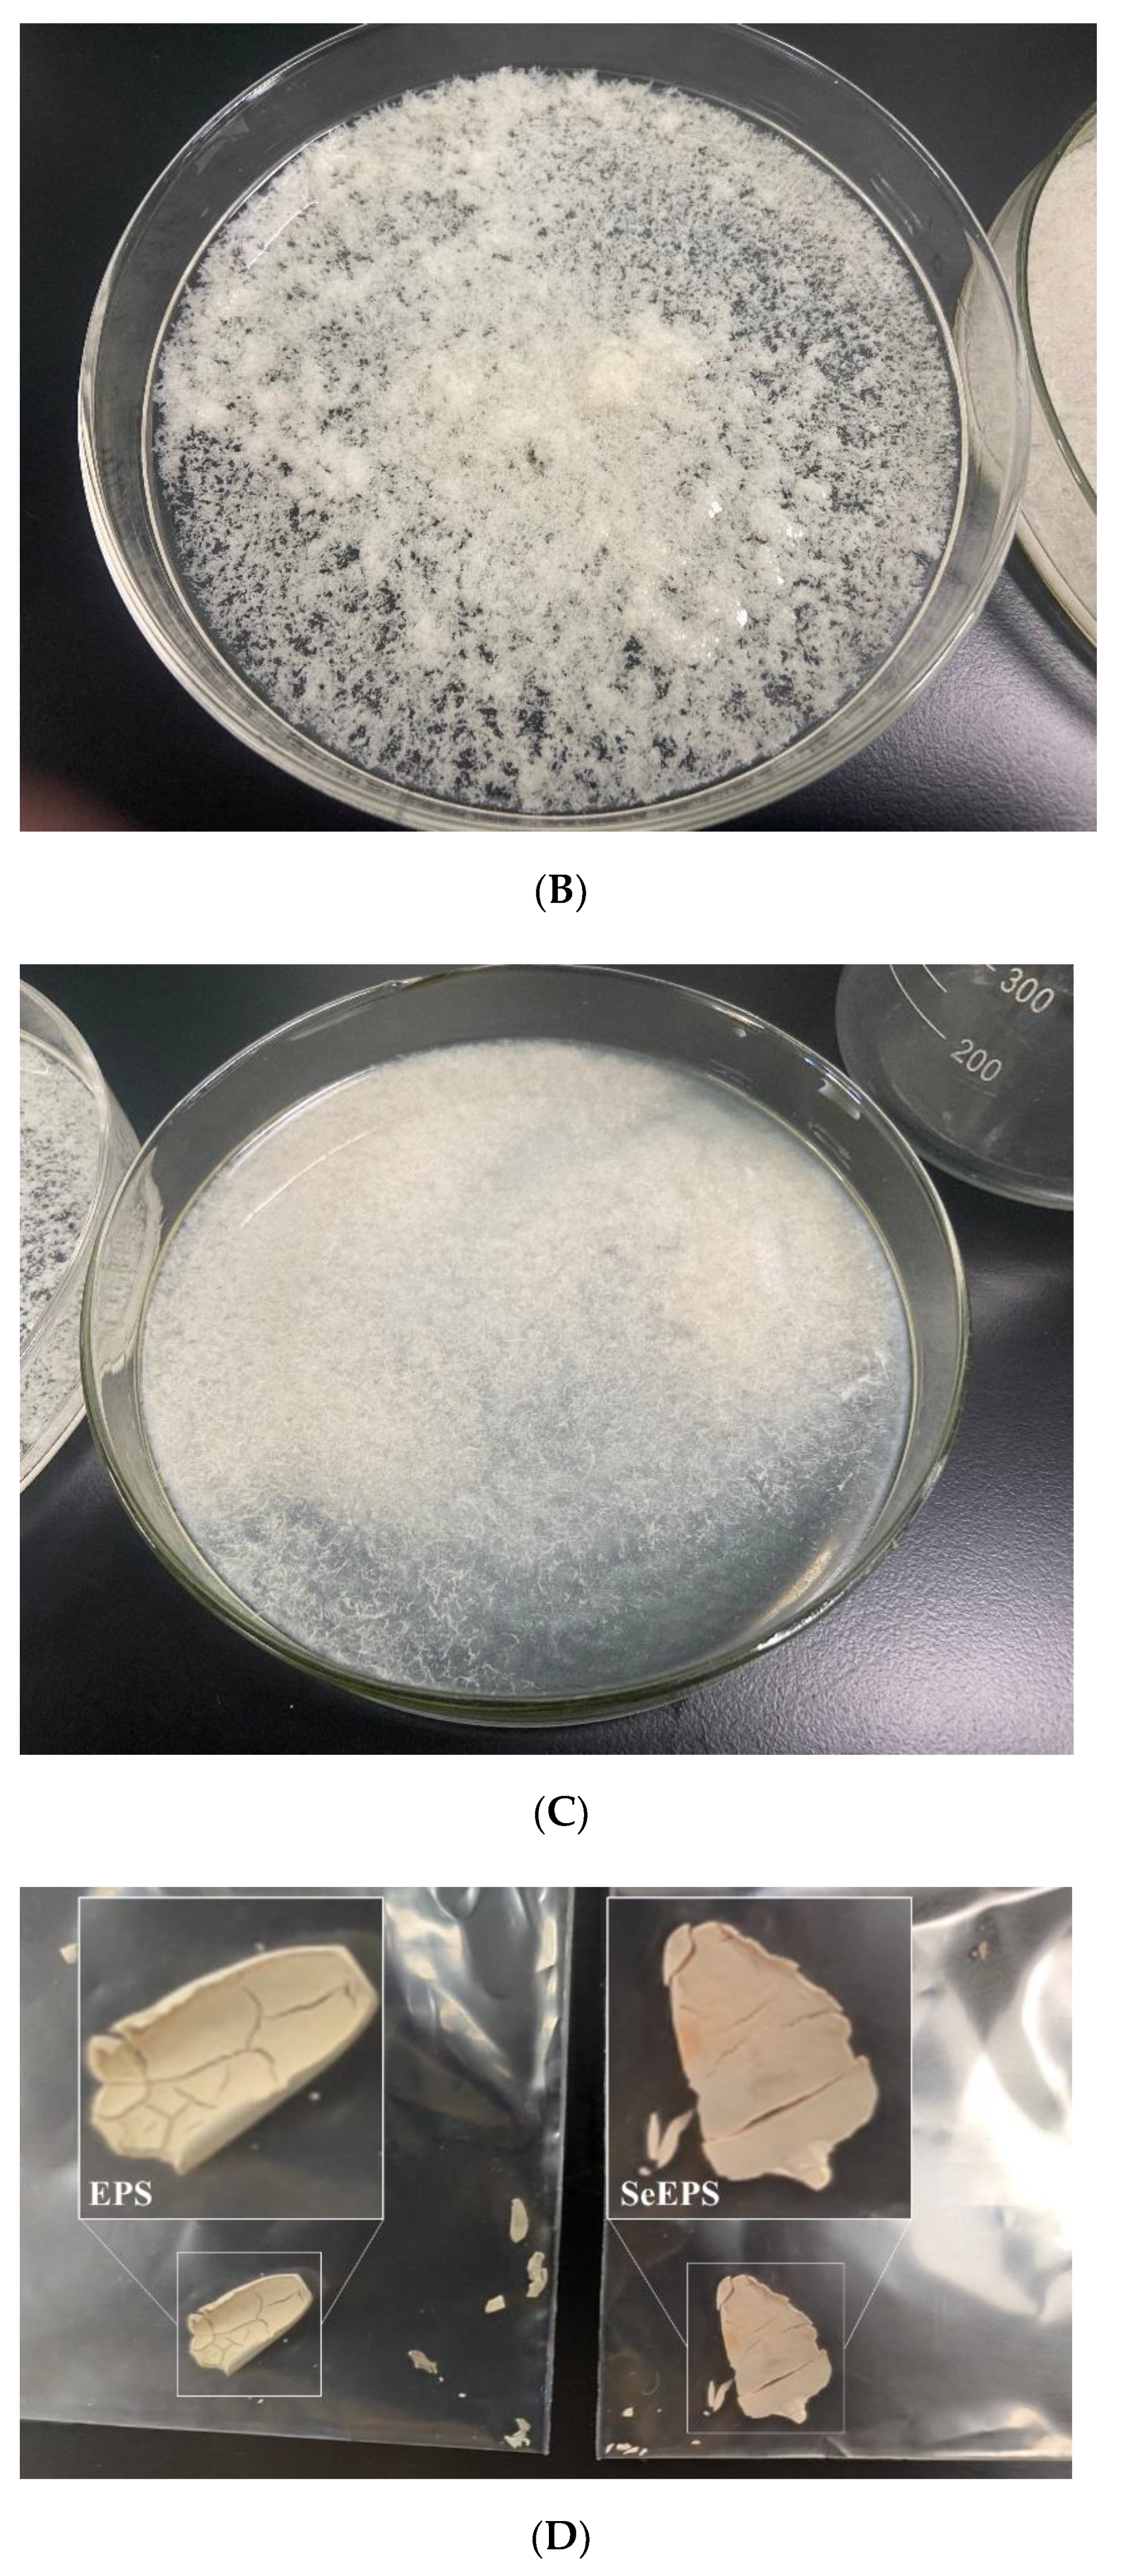

Exopolymer-Functionalized Nanoselenium from Bacillus subtilis SR41: Characterization, Monosaccharide Analysis and Free Radical Scavenging Ability
Abstract
:1. Introduction
2. Materials and Methods
2.1. Chemicals and Reagents
2.2. Bacteria Strains and Cultivation
2.3. Collection and Characterization of SeEPS and EPS
2.4. Preparation of Chemically Synthesized SeNPs
2.5. Fourier Transform Infrared (FTIR) Spectral Analysis and Monosaccharide Composition Analysis
2.6. Determination of the Antioxidant Property
2.7. Statistical Analysis
3. Results
3.1. Components Determination of SeEPS and EPS
3.2. Characterization of SeEPS and EPS
3.3. Monosaccharide Composition Analysis
3.4. Preparation and Characterization of EPS-Se, BSA-Se and Se(0)
3.5. Free Radical Scavenging Activities
4. Discussion
5. Conclusions
Author Contributions
Funding
Institutional Review Board Statement
Informed Consent Statement
Data Availability Statement
Acknowledgments
Conflicts of Interest
References
- Zambonino, M.C.; Quizhpe, E.M.; Jaramillo, F.E.; Rahman, A.; Santiago Vispo, N.; Jeffryes, C.; Dahoumane, S.A. Green Synthesis of Selenium and Tellurium Nanoparticles: Current Trends, Biological Properties and Biomedical Applications. Int. J. Mol. Sci. 2021, 22, 989. [Google Scholar] [CrossRef] [PubMed]
- Wang, G.; Guo, Y.; Yang, G.; Yang, L.; Ma, X.; Wang, K.; Zhu, L.; Sun, J.; Wang, X.; Zhang, H. Mitochondria-Mediated Protein Regulation Mechanism of Polymorphs-Dependent Inhibition of Nanoselenium on Cancer Cells. Sci. Rep. 2016, 6, 31427. [Google Scholar] [CrossRef] [PubMed]
- Xiao, X.; Song, D.; Cheng, Y.; Hu, Y.; Wang, F.; Lu, Z.; Wang, Y. Biogenic nanoselenium particles activate Nrf2-ARE pathway by phosphorylating p38, ERK1/2, and AKT on IPEC-J2 cells. J. Cell Physiol. 2019, 234, 11227–11234. [Google Scholar] [CrossRef]
- Li, D.; Zhou, C.; Ma, J.; Wu, Y.; Kang, L.; An, Q.; Zhang, J.; Deng, K.; Li, J.Q.; Pan, C. Nanoselenium transformation and inhibition of cadmium accumulation by regulating the lignin biosynthetic pathway and plant hormone signal transduction in pepper plants. J Nanobiotechnol. 2021, 19, 316. [Google Scholar] [CrossRef] [PubMed]
- Konieczka, P.; Szkopek, D.; Kinsner, M.; Fotschki, B.; Juskiewicz, J.; Banach, J. Cannabis-derived cannabidiol and nanoselenium improve gut barrier function and affect bacterial enzyme activity in chickens subjected to C. perfringens challenge. Vet. Res. 2020, 51, 141. [Google Scholar] [CrossRef] [PubMed]
- Ren, L.R.; Wu, Z.C.; Ma, Y.; Jian, W.J.; Xiong, H.J.; Zhou, L.N. Preparation and growth-promoting effect of selenium nanoparticles capped by polysaccharide-protein complexes on tilapia. J. Sci. Food Agric. 2021, 101, 476–485. [Google Scholar] [CrossRef] [PubMed]
- Sheikhalipour, M.; Esmaielpour, B.; Behnamian, M.; Gohari, G.; Giglou, M.T.; Vachova, P.; Rastogi, A.; Brestic, M.; Skalicky, M. Chitosan-Selenium Nanoparticle fCs-Se NP) Foliar Spray Alleviates Salt Stress in Bitter Melon. Nanomaterials 2021, 11, 684. [Google Scholar] [CrossRef]
- Liao, W.Z.; Yu, Z.Q.; Lin, Z.H.; Lei, Z.G.; Ning, Z.X.; Regenstein, J.M.; Yang, J.G.; Ren, J.Y. Biofunctionalization of Selenium Nanoparticle with Dictyophora Indusiata Polysaccharide and Its Antiproliferative Activity through Death-Receptor and Mitochondria-Mediated Apoptotic Pathways. Sci. Rep. 2015, 5, 18629. [Google Scholar] [CrossRef]
- Song, D.G.; Cheng, Y.Z.; Li, X.X.; Wang, F.Q.; Lu, Z.Q.; Xiao, X.; Wang, Y.Z. Biogenic Nanoselenium Particles Effectively Attenuate Oxidative Stress-Induced Intestinal Epithelial Barrier Injury by Activating the Nrf2 Antioxidant Pathway. ACS Appl. Mater. Interfaces 2017, 9, 14724–14740. [Google Scholar] [CrossRef]
- Tugarova, A.V.; Kamnev, A.A. Proteins in microbial synthesis of selenium nanoparticles. Talanta 2017, 174, 539–547. [Google Scholar] [CrossRef]
- Dobias, J.; Suvorova, E.I.; Bernier-Latmani, R. Role of proteins in controlling selenium nanoparticle size. Nanotechnology 2011, 22, 195605. [Google Scholar] [CrossRef] [PubMed]
- Song, D.; Li, X.; Cheng, Y.; Xiao, X.; Lu, Z.; Wang, Y.; Wang, F. Aerobic biogenesis of selenium nanoparticles by Enterobacter cloacae Z0206 as a consequence of fumarate reductase mediated selenite reduction. Sci. Rep. 2017, 7, 3239. [Google Scholar] [CrossRef] [PubMed]
- Jia, H.L.; Huang, S.W.; Cheng, S.; Zhang, X.W.; Chen, X.; Zhang, Y.S.; Wang, J.; Wu, L.F. Novel mechanisms of selenite reduction in Bacillus subtilis 168: Confirmation of multiple-pathway mediated remediation based on transcriptome analysis. J. Hazard. Mater. 2022, 433, 128834. [Google Scholar] [CrossRef] [PubMed]
- Liang, X.J.; Perez, M.A.M.J.; Nwoko, K.C.; Egbers, P.; Feldmann, J.; Csetenyi, L.; Gadd, G.M. Fungal formation of selenium and tellurium nanoparticles. Appl. Microbiol. Biotechnol. 2019, 103, 7241–7259. [Google Scholar] [CrossRef] [PubMed]
- Elahian, F.; Reiisi, S.; Shahidi, A.; Mirzaei, S.A. High-throughput bioaccumulation, biotransformation, and production of silver and selenium nanoparticles using genetically engineered Pichia pastoris. Nanomedicine 2017, 13, 853–861. [Google Scholar] [CrossRef] [PubMed]
- Vinu, D.; Govindaraju, K.; Vasantharaja, R.; Nisa, S.A.; Kannan, M.; Anand, K.V. Biogenic zinc oxide, copper oxide and selenium nanoparticles: Preparation, characterization and their anti-bacterial activity against Vibrio parahaemolyticus. J. Nanostruct. Chem. 2021, 11, 271–286. [Google Scholar] [CrossRef]
- Xu, C.L.; Qiao, L.; Ma, L.; Yan, S.Q.; Guo, Y.; Dou, X.N.; Zhang, B.H.; Roman, A. Biosynthesis of Polysaccharides-Capped Selenium Nanoparticles Using Lactococcus lactis NZ9000 and Their Antioxidant and Anti-inflammatory Activities. Front. Microbiol. 2019, 10, 1632. [Google Scholar] [CrossRef]
- Shoeibi, S.; Mashreghi, M. Biosynthesis of selenium nanoparticles using Enterococcus faecalis and evaluation of their antibacterial activities. J. Trace. Elem. Med. Bio. 2017, 39, 135–139. [Google Scholar] [CrossRef]
- Fernandez-Llamosas, H.; Castro, L.; Blazquez, M.L.; Diaz, E.; Carmona, M. Biosynthesis of selenium nanoparticles by Azoarcus sp. CIB. Microb. Cell Fact. 2016, 15, 109. [Google Scholar] [CrossRef]
- Ali, F.; Saeed, K.; Fatemeh, H. Nano-Bio Selenium Synthesized by Bacillus subtilis Modulates Broiler Performance, Intestinal Morphology and Microbiota, and Expression of Tight Junction’s Proteins. Biol. Trace. Elem. Res. 2022, 200, 1811–1825. [Google Scholar] [CrossRef]
- Borah, S.N.; Goswami, L.; Sen, S.; Sachan, D.; Sarma, H.; Montes, M.; Peralta-Videa, J.R.; Pakshirajan, K.; Narayan, M. Selenite bioreduction and biosynthesis of selenium nanoparticles by Bacillus paramycoides SP3 isolated from coal mine overburden leachate. Environ. Pollut. 2021, 285, 117519. [Google Scholar] [CrossRef]
- Fischer, S.; Krause, T.; Lederer, F.; Merroun, M.L.; Shevchenko, A.; Hubner, R.; Firkala, T.; Stumpf, T.; Jordan, N.; Jain, R. Bacillus safensis JG-B5T affects the fate of selenium by extracellular production of colloidally less stable selenium nanoparticles. J. Hazard. Mater. 2020, 384, 121146. [Google Scholar] [CrossRef] [PubMed]
- Yang, J.; Zhang, M.; Zhou, Y. Effects of selenium-enriched Bacillus sp. compounds on growth performance, antioxidant status, and lipid parameters breast meat quality of Chinese Huainan partridge chicks in winter cold stress. Lipids Health Dis. 2019, 18, 63. [Google Scholar] [CrossRef] [PubMed]
- Ullah, A.; Yin, X.; Wang, F.; Xu, B.; Mirani, Z.A.; Xu, B.; Chan, M.W.H.; Ali, A.; Usman, M.; Ali, N.; et al. Biosynthesis of Selenium Nanoparticles (via Bacillus subtilis BSN313), and Their Isolation, Characterization, and Bioactivities. Molecules 2021, 26, 5559. [Google Scholar] [CrossRef] [PubMed]
- Wang, Y.; Yu, Y.; Duan, Y.; Wang, Q.; Cong, X.; He, Y.; Gao, C.; Hafeez, M.; Jan, S.; Rasheed, S.M.; et al. Enhancing the Activity of Carboxymethyl Cellulase Enzyme Using Highly Stable Selenium Nanoparticles Biosynthesized by Bacillus paralicheniformis Y4. Molecules 2022, 27, 4585. [Google Scholar] [CrossRef] [PubMed]
- Bao, P.; Xiao, K.Q.; Wang, H.J.; Xu, H.; Xu, P.P.; Jia, Y.; Haggblom, M.M.; Zhu, Y.G. Characterization and Potential Applications of a Selenium Nanoparticle Producing and Nitrate Reducing Bacterium Bacillus oryziterrae sp. nov. Sci. Rep. 2016, 6, 34054. [Google Scholar] [CrossRef]
- Xiao, X.; Cheng, Y.; Song, D.; Li, X.; Hu, Y.; Lu, Z.; Wang, F.; Wang, Y. Selenium-enriched Bacillus paralicheniformis SR14 attenuates H2O2-induced oxidative damage in porcine jejunum epithelial cells via the MAPK pathway. Appl. Microbiol. Biotechnol. 2019, 103, 6231–6243. [Google Scholar] [CrossRef]
- Cheng, Y.Z.; Xiao, X.; Li, X.X.; Song, D.G.; Lu, Z.Q.; Wang, F.Q.; Wang, Y.Z. Characterization, antioxidant property and cytoprotection of exopolysaccharide-capped elemental selenium particles synthesized by Bacillus paralicheniformis SR14. Carbohyd. Polym. 2017, 178, 18–26. [Google Scholar] [CrossRef]
- Li, Y.H.; Li, X.L.; Wong, Y.S.; Chen, T.F.; Zhang, H.B.; Liu, C.R.; Zheng, W.J. The reversal of cisplatin-induced nephrotoxicity by selenium nanoparticles functionalized with 11-mercapto-1-undecanol by inhibition of ROS-mediated apoptosis. Biomaterials 2011, 32, 9068–9076. [Google Scholar] [CrossRef]
- Kai, L.; Zong, X.; Jiang, Q.; Lu, Z.; Wang, F.; Wang, Y.; Wang, T.; Jin, M. Protective effects of polysaccharides from Atractylodes macrocephalae Koidz. against dextran sulfate sodium induced intestinal mucosal injury on mice. Int. J. Biol. Macromol. 2022, 195, 142–151. [Google Scholar] [CrossRef]
- Wang, Y.; Ye, Q.; Sun, Y.; Jiang, Y.; Meng, B.; Du, J.; Chen, J.; Tugarova, A.V.; Kamnev, A.A.; Huang, S. Selenite Reduction by Proteus sp. YS02: New Insights Revealed by Comparative Transcriptomics and Antibacterial Effectiveness of the Biogenic Se Nanoparticles. Front. Microbiol. 2022, 13, 845321. [Google Scholar] [CrossRef] [PubMed]
- Hou, G.; Chen, X.; Li, J.; Ye, Z.; Zong, S.; Ye, M. Physicochemical properties, immunostimulatory activity of the Lachnum polysaccharide and polysaccharide-dipeptide conjugates. Carbohydr. Polym. 2019, 206, 446–454. [Google Scholar] [CrossRef] [PubMed]
- Tugarova, A.V.; Dyatlova, Y.A.; Kenzhegulov, O.A.; Kamnev, A.A. Poly-3-hydroxybutyrate synthesis by different Azospirillum brasilense strains under varying nitrogen deficiency: A comparative in-situ FTIR spectroscopic analysis. Spectrochim. Acta A Mol. Biomol. Spectrosc. 2021, 252, 119458. [Google Scholar] [CrossRef] [PubMed]
- Kamnev, A.A.; Dyatlova, Y.A.; Kenzhegulov, O.A.; Vladimirova, A.A.; Mamchenkova, P.V.; Tugarova, A.V. Fourier Transform Infrared (FTIR) Spectroscopic Analyses of Microbiological Samples and Biogenic Selenium Nanoparticles of Microbial Origin: Sample Preparation Effects. Molecules 2021, 26, 1146. [Google Scholar] [CrossRef]
- Figueiro, S.D.; Goes, M.C.; Moreira, R.A.; Sombra, A.S.B. On the physico-chemical and dielectric properties of glutaraldehyde crosslinked galactomannan-collagen films. Carbohyd. Polym. 2004, 56, 313–320. [Google Scholar] [CrossRef]
- Ferreira, R.L.U.; Sena-Evangelista, K.C.M.; De Azevedo, E.P.; Pinheiro, F.I.; Cobucci, R.N.; Pedrosa, L.F.C. Selenium in Human Health and Gut Microflora: Bioavailability of Selenocompounds and Relationship With Diseases. Front. Nutr. 2021, 8, 685317. [Google Scholar] [CrossRef]
- Sobiech, P.; Zarczynska, K. The influence of selenium deficiency on chosen biochemical parameters and histopathological changes in muscles of goat kids. Pol. J. Vet. Sci. 2020, 23, 267–279. [Google Scholar]
- Rayman, M.P. Selenium and human health. Lancet 2012, 379, 1256–1268. [Google Scholar] [CrossRef]
- Sun, H.J.; Rathinasabapathi, B.; Wu, B.; Luo, J.; Pu, L.P.; Ma, L.Q. Arsenic and selenium toxicity and their interactive effects in humans. Environ. Int. 2014, 69, 148–158. [Google Scholar] [CrossRef]
- Ojeda, J.J.; Merroun, M.L.; Tugarova, A.V.; Lampis, S.; Kamnev, A.A.; Gardiner, P.H.E. Developments in the study and applications of bacterial transformations of selenium species. Crit. Rev. Biotechnol. 2020, 40, 1250–1264. [Google Scholar] [CrossRef]
- Zeng, S.Q.; Ke, Y.; Liv, Y.X.; Shen, Y.B.; Zhang, L.; Li, C.; Liu, A.P.; Shen, L.; Hu, X.J.; Wu, H.J.; et al. Synthesis and antidiabetic properties of chitosan-stabilized selenium nanoparticles. Colloid. Surface B 2018, 170, 115–121. [Google Scholar] [CrossRef] [PubMed]
- Chung, S.; Zhou, R.H.; Webster, T.J. Green Synthesized BSA-Coated Selenium Nanoparticles Inhibit Bacterial Growth While Promoting Mammalian Cell Growth. Int. J. Nanomed. 2020, 15, 115–124. [Google Scholar] [CrossRef] [PubMed]
- Saini, V.; Singh, A.; Shukla, R.; Jain, K.; Yadav, A.K. Silymarin-Encapsulated Xanthan Gum-Stabilized Selenium Nanocarriers for Enhanced Activity Against Amyloid Fibril Cytotoxicity. AAPS Pharm. Sci. Tech. 2022, 23, 125. [Google Scholar] [CrossRef] [PubMed]
- Siddiqui, S.A.; Blinov, A.V.; Serov, A.V.; Gvozdenko, A.A.; Kravtsov, A.A.; Nagdalian, A.A.; Raffa, V.V.; Maglakelidze, D.G.; Blinova, A.A.; Kobina, A.V.; et al. Effect of Selenium Nanoparticles on Germination of Hordeum Vulgare Barley Seeds. Coatings 2021, 11, 862. [Google Scholar] [CrossRef]
- Zhang, J.N.; Zhou, X.B.; Yu, Q.Q.; Yang, L.C.; Sun, D.D.; Zhou, Y.H.; Liu, J. Epigallocatechin-3-gallate (EGCG)-Stabilized Selenium Nanoparticles Coated with Tet-1 Peptide To Reduce Amyloid-beta Aggregation and Cytotoxicity. ACS Appl. Mater. Interfaces 2014, 6, 8475–8487. [Google Scholar] [CrossRef] [PubMed]
- Oremland, R.S.; Herbel, M.J.; Blum, J.S.; Langley, S.; Beveridge, T.J.; Ajayan, P.M.; Sutto, T.; Ellis, A.V.; Curran, S. Structural and spectral features of selenium nanospheres produced by Se-respiring bacteria. Appl. Environ. Microb. 2004, 70, 52–60. [Google Scholar] [CrossRef]
- Sonkusre, P. Specificity of Biogenic Selenium Nanoparticles for Prostate Cancer Therapy With Reduced Risk of Toxicity: An in vitro and in vivo Study. Front. Oncol. 2019, 9, 1541. [Google Scholar] [CrossRef]
- Yan, S.; Qiao, L.; Dou, X.; Song, X.; Chen, Y.; Zhang, B.; Xu, C. Biogenic selenium nanoparticles by Lactobacillus casei ATCC 393 alleviate the intestinal permeability, mitochondrial dysfunction and mitophagy induced by oxidative stress. Food Funct. 2021, 12, 7068–7080. [Google Scholar] [CrossRef]
- Eswayah, A.S.; Hondow, N.; Scheinost, A.C.; Merroun, M.; Romero-Gonzalez, M.; Smith, T.J.; Gardiner, P.H.E. Methyl Selenol as a Precursor in Selenite Reduction to Se/S Species by Methane-Oxidizing Bacteria. Appl. Environ. Microb. 2019, 85, e01379-19. [Google Scholar] [CrossRef]
- Tsivileva, O.; Pozdnyakov, A.; Ivanova, A. Polymer Nanocomposites of Selenium Biofabricated Using Fungi. Molecules 2021, 26, 3657. [Google Scholar] [CrossRef]
- Zhou, N.; Long, H.; Wang, C.; Yu, L.; Zhao, M.; Liu, X. Research progress on the biological activities of selenium polysaccharides. Food Funct. 2020, 11, 4834–4852. [Google Scholar] [CrossRef] [PubMed]
- Richaud, A.; Mendez, F.; Barba-Behrens, N.; Florian, P.; Medina-Campos, O.N.; Pedraza-Chaverri, J. Electrophilic Modulation of the Superoxide Anion Radical Scavenging Ability of Copper(II) Complexes with 4-Methyl Imidazole. J. Phys. Chem. A 2021, 125, 2394–2401. [Google Scholar] [CrossRef] [PubMed]
- Wu, L.; Ishigaki, Y.; Zeng, W.; Harimoto, T.; Yin, B.; Chen, Y.; Liao, S.; Liu, Y.; Sun, Y.; Zhang, X.; et al. Generation of hydroxyl radical-activatable ratiometric near-infrared bimodal probes for early monitoring of tumor response to therapy. Nat. Commun. 2021, 12, 6145. [Google Scholar] [CrossRef] [PubMed]
- Rzhepakovsky, I.V.; Areshidze, D.A.; Avanesyan, S.S.; Grimm, W.D.; Filatova, N.V.; Kalinin, A.V.; Kochergin, S.G.; Kozlova, M.A.; Kurchenko, V.P.; Sizonenko, M.N.; et al. Phytochemical Characterization, Antioxidant Activity, and Cytotoxicity of Methanolic Leaf Extract of Chlorophytum Comosum (Green Type) (Thunb.) Jacq. Molecules 2022, 27, 762. [Google Scholar] [CrossRef]
- Skalickova, S.; Milosavljevic, V.; Cihalova, K.; Horky, P.; Richtera, L.; Adam, V. Selenium nanoparticles as a nutritional supplement. Nutrition 2017, 33, 83–90. [Google Scholar] [CrossRef]
- Ashengroph, M.; Hosseini, S.R. A newly isolated Bacillus amyloliquefaciens SRB04 for the synthesis of selenium nanoparticles with potential antibacterial properties. Int. Microbiol. 2021, 24, 103–114. [Google Scholar] [CrossRef]

| Item | SeEPS | EPS |
|---|---|---|
| Dry matter (g/L) | 37.8 ± 0.3 | 40.3 ± 0.2 |
| Protein contents (%) | 24.7 ± 1.1 | 23.5 ± 1.7 |
| Sugar contents (%) | 45.2 ± 0.1 | 45.4 ± 0.1 |
| Ash content (%) | 8.4 ± 0.1 | 8.1 ± 0.2 |
| Se contents (mg/kg) | 554.7 ± 9.5 | 0 |
| Item | SeEPS | EPS |
|---|---|---|
| Mannose | 34.9 ± 2.8% | 34.2 ± 2.8% |
| Amino glucose | 8.8 ± 1.2% | 7.7 ± 1.0% |
| Ribose | 10.1 ± 0.3% | 11.1 ± 1.1% |
| Galactosamine | 0.2 ± 0.1% | - |
| Glucose | 37.8 ± 0.8% | 35.4 ± 4.7% |
| Galactose | 2.8 ± 0.3% | 6.9 ± 5.6% |
| Unknown | 4.3 ± 0.7% | 3.1 ± 0.5% |
| Item | Biogenic Products by SR41 | Chemically Synthesized Products | |||
|---|---|---|---|---|---|
| SeEPS | EPS | BSA-Se Solution | EPS-Se Suspension | Se(0) Suspension | |
| Selenium contents (mg/L) | 20.1 ± 0.3 | 0 | 19.9 ± 0.2 | 20.0 ± 0.1 | 20.0 ± 0.2 |
| Protein contents (g/L) | 9.3 ± 0.1 | 9.3 ± 0.1 | 9.2 ± 0.2 | 9.3 ± 0.0 | 0 |
| Sugar contents (g/L) | 17.5± 0.3 | 18.1 ± 0.1 | 0 | 18.1± 0.2 | 0 |
| Average size of nanoselenium (nm) | 67.0 ± 0.6 | - | 56.8 ± 0.2 | 635 ± 21 | 762 ± 18 |
Publisher’s Note: MDPI stays neutral with regard to jurisdictional claims in published maps and institutional affiliations. |
© 2022 by the authors. Licensee MDPI, Basel, Switzerland. This article is an open access article distributed under the terms and conditions of the Creative Commons Attribution (CC BY) license (https://creativecommons.org/licenses/by/4.0/).
Share and Cite
Wang, F.; Du, M.; Kai, L.; Du, S.; Hu, W.; Wang, Y.; Cheng, Y. Exopolymer-Functionalized Nanoselenium from Bacillus subtilis SR41: Characterization, Monosaccharide Analysis and Free Radical Scavenging Ability. Polymers 2022, 14, 3523. https://doi.org/10.3390/polym14173523
Wang F, Du M, Kai L, Du S, Hu W, Wang Y, Cheng Y. Exopolymer-Functionalized Nanoselenium from Bacillus subtilis SR41: Characterization, Monosaccharide Analysis and Free Radical Scavenging Ability. Polymers. 2022; 14(17):3523. https://doi.org/10.3390/polym14173523
Chicago/Turabian StyleWang, Fengqin, Man Du, Lixia Kai, Shuai Du, Weilian Hu, Yizhen Wang, and Yuanzhi Cheng. 2022. "Exopolymer-Functionalized Nanoselenium from Bacillus subtilis SR41: Characterization, Monosaccharide Analysis and Free Radical Scavenging Ability" Polymers 14, no. 17: 3523. https://doi.org/10.3390/polym14173523
APA StyleWang, F., Du, M., Kai, L., Du, S., Hu, W., Wang, Y., & Cheng, Y. (2022). Exopolymer-Functionalized Nanoselenium from Bacillus subtilis SR41: Characterization, Monosaccharide Analysis and Free Radical Scavenging Ability. Polymers, 14(17), 3523. https://doi.org/10.3390/polym14173523

